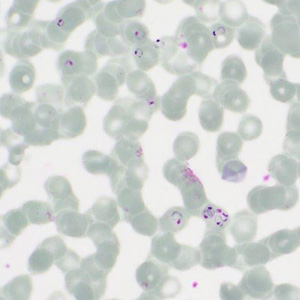
Case413_C.jpg Figure C

Case #413 – February 2016
A 20-year-old male from Ghana presented to a hospital with flu-like illness, hepatomegaly, thrombocytopenia, a low absolute lymphocyte count (ALC), an elevated absolute monocyte count (AMC), and lymphocyte reactive forms. A blood specimen was collected to perform the BinaxNOW® Malaria Rapid Diagnostic Test (RDT) and to prepare thick and thin blood smears to be stained with Giemsa and examined. Figure A shows the result of the RDT. Figure B shows an example of what was observed on a thick smear at 1000x magnification with oil; Figures C–I show what was observed on a stained thin blood smear at the same magnification. What is your diagnosis? Based on what criteria?

Figure A

Figure D

Figure G

Figure B

Figure E

Figure H
Figure C

Figure F

Figure I
This case and images were kindly provided by the Cadham Provincial Laboratory, Manitoba, Canada.
DPDx is an educational resource designed for health professionals and laboratory scientists. For an overview including prevention, control, and treatment visit www.cdc.gov/parasites/.